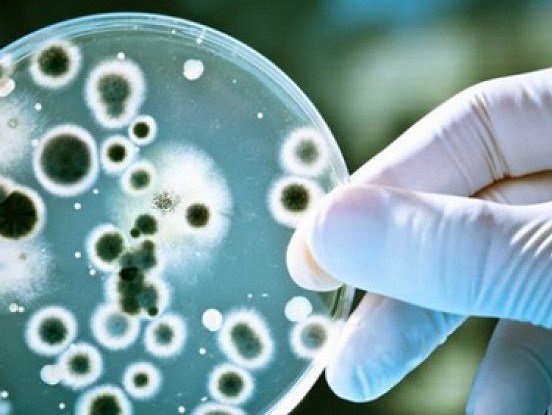
Lūk kā atbrīvoties no baktērijām, kas izraisa dedzināšanas sajūtu un vēdera uzpūšanos

21. gadsimtā, kad saslimšana ar vēzis pieaug ļoti strauji, aizvien lielāka kļūst vajadzība pēc alternatīvām ārstēšanas metodēm. Šobrīd tiek veikts milzīgs daudzums pētījumu cīņā...
Kategorija: Veselība un skaistums
Šis kurkuma kokteilis ir ne tikai skaists un garšīgs, bet arī ļoti dziedinošs. Kurkuma, ingvers un kanēlis, kā arī superprodukti - bišu ziedputekšņi un...
Vienkārši padomi kā tikt galā ar kuņģa problēmām mājas apstākļos. Jūs nomoka uzpūties vēders? Turpmāk uzskaitīti daži iemesli, kas noved pie kuņģa darbības traucējumiem,...
Runa būs par osteoporozi. Kalcijam jānokļūst kaulos, tādēļ organisms to saņem kopā ar barību un no kuņģa nokļūst asinīs. Par kalcija uzsūkšanos atbild vitamīni...
Tas ir svarīgi! Pazīmes un simptomi. Kā zināms, cilvēkiem mēdz būt H. pylori infekcija, bet viņi par to nemaz nezina, jo nav nekādu simptomu....
Saka, ka acis ir dvēseles spogulis. Tāpat kā acis ataino mūsu iekšējo pasauli, tā āda parāda cilvēka stāvokli kopumā. Ķīniešu mediķi uzskata, ka katrs...
Daudzas no mums cīnās ar hormonālo disbalansu, menopauzes simptomiem un hormonālajām izmaiņām. Mūsdienās eksistē pat vesela filozofija par mūsu saikni ar dabu, tās mēness...
Slimošana bijusi aktuāla tēma vienmēr. Lai cik daudz pūļu ieguldītu imunitātes stiprināšanā, no saslimšanas pilnībā nevar izvairīties neviens, taču varam ar šiem padomiem vairāk...
Slimības atnāk ne jau tāpēc, ka slikta ekoloģija, vai netīrs ūdens, vai plastmasas ēdiens, un mēs par maz kustamies. Nekādā ziņā! Tas ir pirmkārt....
Ķirbis. Ikviens no mums zina, kā izskatās šī lielā oga. Taču ne visi zina par tās vērtīgajām īpašībām. Nolēmu pamēģināt to ēst katru dienu...
Lapa 19 no 62